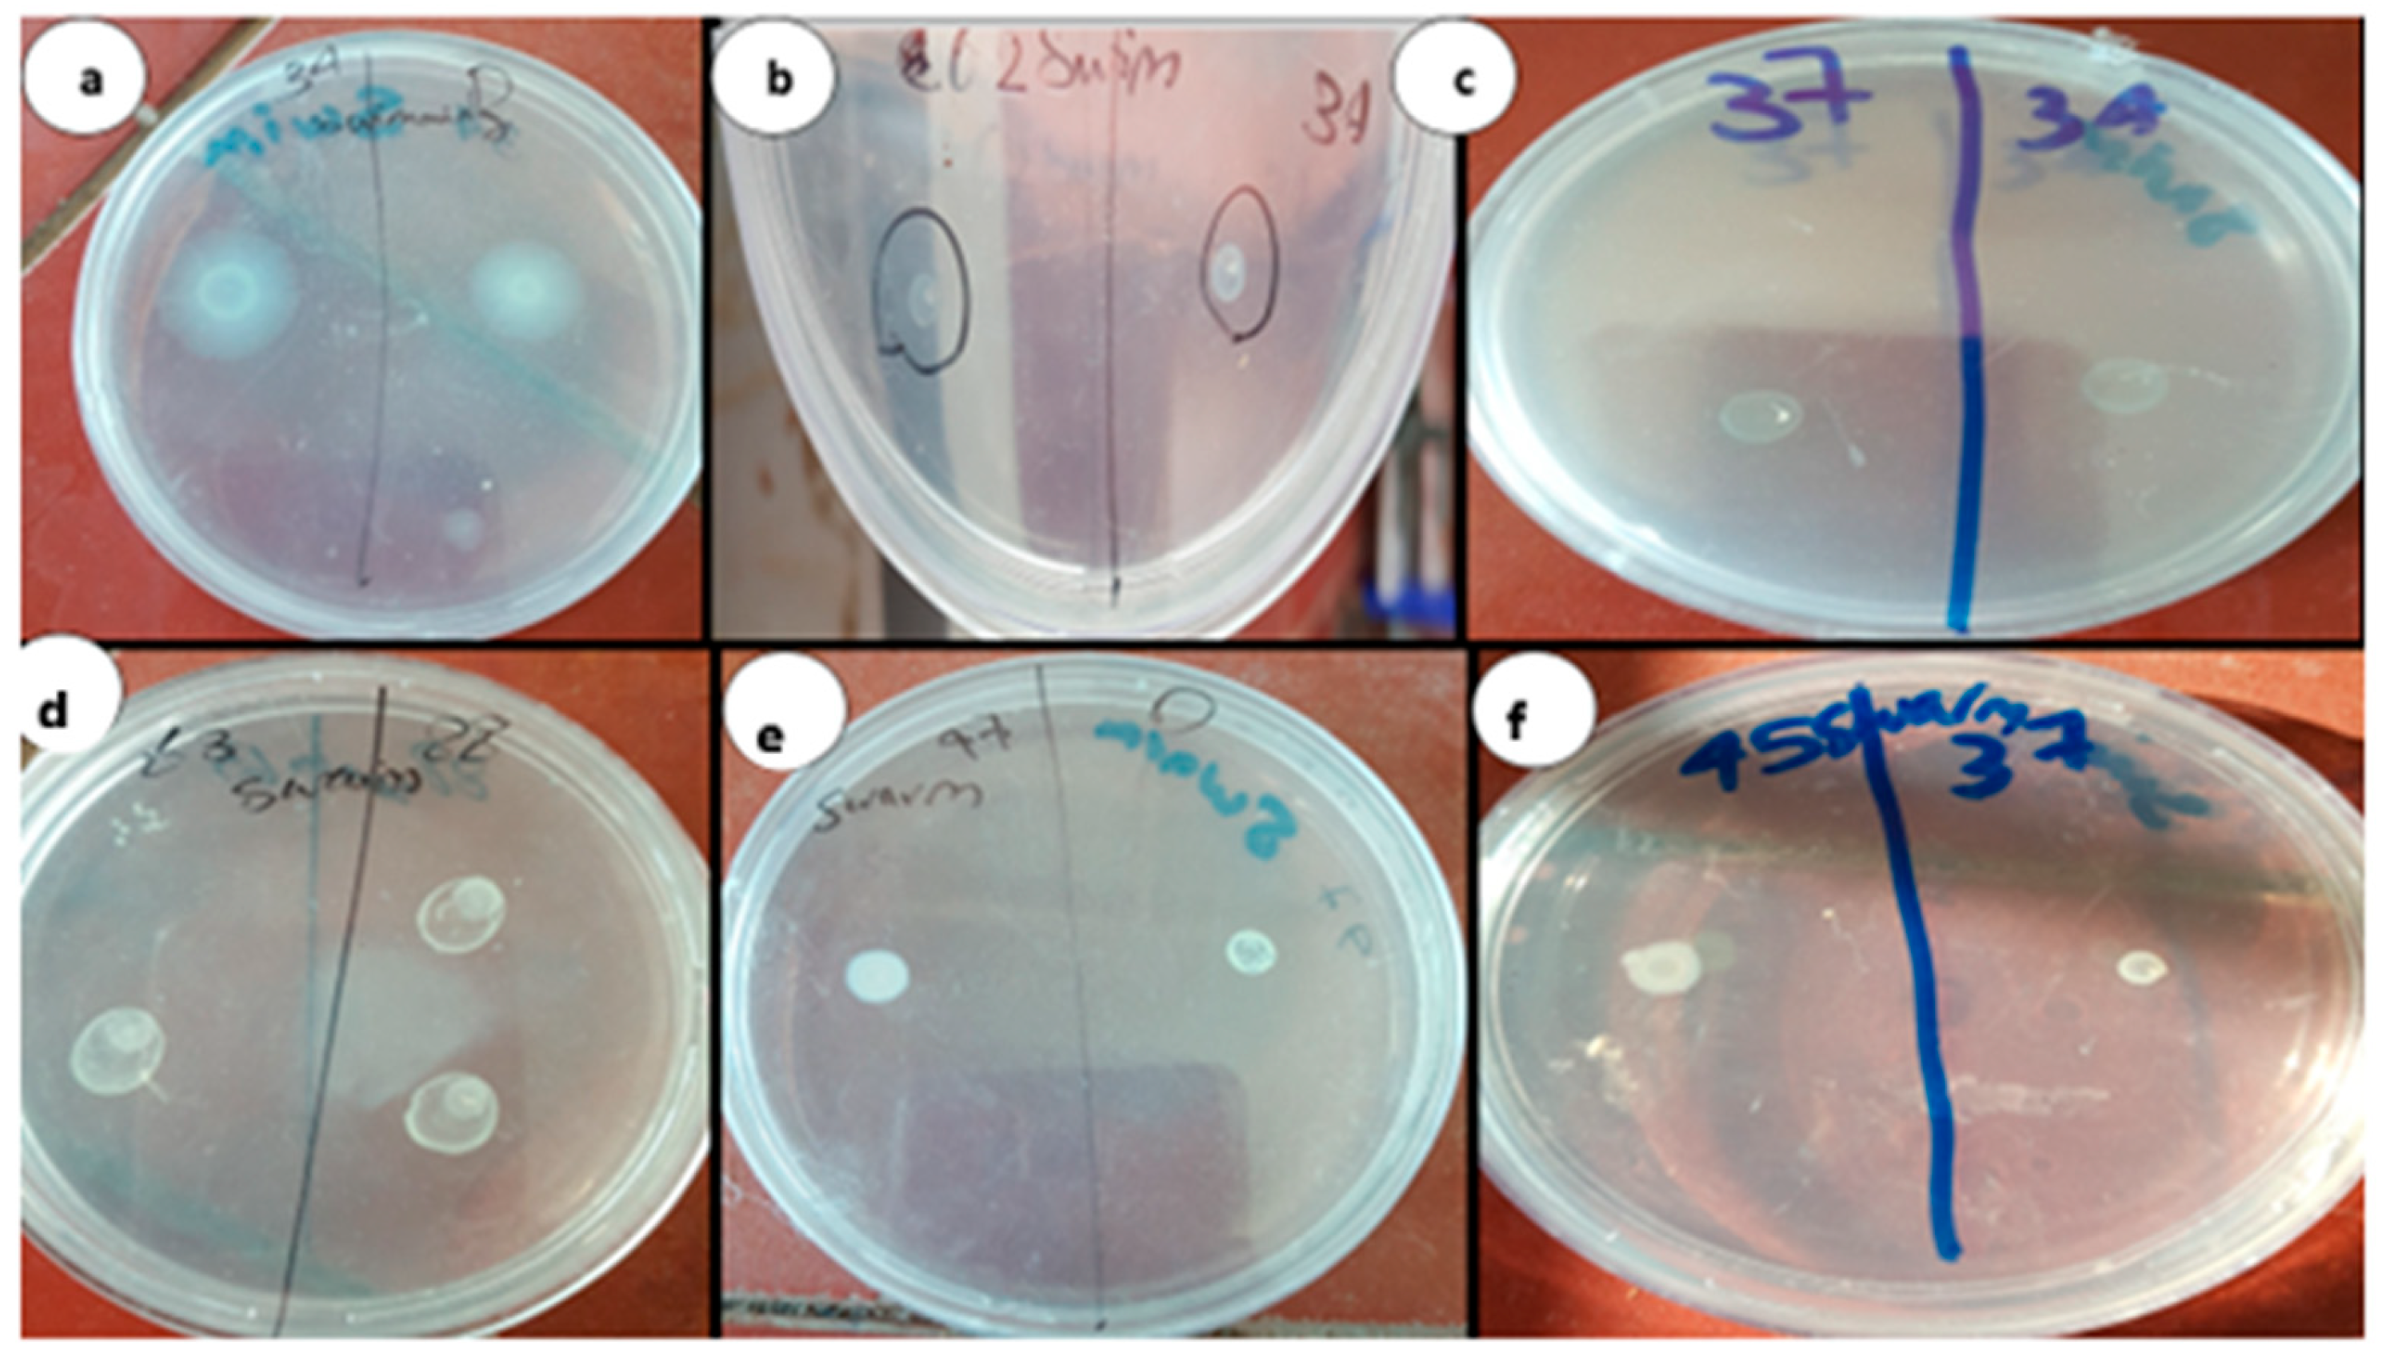
Life 14 00481 g001

Chitosan–Aspirin Combination Inhibits Quorum-Sensing Synthases (lasI and rhlI) in Pseudomonas aeruginosa
Abstract
1. Background
2. Methods
2.1. Bacterial Strains and Media
2.2. Inhibitory Activity of Aspirin and Chitosan–Aspirin against P. aeruginosa Virulence Factors
2.2.1. Determination of MICs of Aspirin and Chitosan–Aspirin
2.2.2. Phenotypic Identification of Aspirin and Chitosan–Aspirin Inhibitory Activity
2.2.3. Genotypic Identification of Chitosan–Aspirin Inhibitory Activity
2.3. Homology Modeling
2.3.1. Homology Model Validation
2.3.2. Molecular Docking
2.4. Statistical Analyses
3. Results
3.1. Inhibitory Activity of Aspirin and Chitosan–Aspirin against P. aeruginosa Virulence Factors
3.1.1. MICs of Aspirin and Chitosan–Aspirin
3.1.2. Phenotypic Identification of Aspirin and Chitosan–Aspirin’s Inhibitory Activity
3.1.3. Genotypic Identification of Chitosan–Aspirin’s Inhibitory Activity
3.2. Molecular Docking Study
4. Discussion
5. Conclusions
Author Contributions
Funding
Institutional Review Board Statement
Informed Consent Statement
Data Availability Statement
Conflicts of Interest
References
- Kalferstova, L.; Dedeckova, K.V.; Antuskova, M.; Melter, O.; Drevinek, P. How and why to monitor P. aeruginosa infections in the long term at a cystic fibrosis centre. J. Hosp. Infect. 2016, 92, 54–60. [Google Scholar] [CrossRef]
- Li, S.; Yao, J.; Li, H. Plantain herb extracts significantly attenuate the quorum sensing-controlled virulence factors and inhibit biofilm formation in P. aeruginosa PAO1. E3S Web Conf. 2019, 78, 01004. [Google Scholar] [CrossRef]
- Sionov, R.V.; Steinberg, D. Targeting the Holy Triangle of Quorum Sensing, Biofilm Formation, and Antibiotic Resistance in Pathogenic Bacteria. Microorganisms 2022, 10, 1239. [Google Scholar] [CrossRef] [PubMed]
- da Silva, D.P.; Schofield, M.C.; Parsek, M.R.; Tseng, B.S. An update on the sociomicrobiology of quorum sensing in gram-negative biofilm development. Pathogens 2017, 6, 51. [Google Scholar] [CrossRef]
- Ammar, Y.A.; Ragab, A.; Migahed, M.A.; Al-Sharbasy, S.; Salem, M.A.; Riad, O.K.M.; Selim, H.M.R.M.; Abd-Elmaksoud, G.A.; Abusaif, M.S. Design, green synthesis, and quorum sensing quenching potential of novel 2-oxo-pyridines containing a thiophene/furan scaffold and targeting a LasR gene on P. aeruginosa. RSC Adv. 2023, 13, 27363–27384. [Google Scholar] [CrossRef] [PubMed]
- Singh, B.; Singh, B.; Singh, A.; Khan, W.; Naqvi, A.; Singh, H. Mycofabricated biosilver nanoparticles interrupt P. aeruginosa quorum sensing systems. Sci. Rep. 2015, 5, 13719. [Google Scholar] [CrossRef] [PubMed]
- Srivastava, A.; Singh, B.N.; Deepak, D.; Rawat, A.K.S. Colostrum hexasaccharide, a Novel S. aureus quorum-sensing inhibitor. Antimicrob. Agents Chemother. 2015, 59, 2169–2178. [Google Scholar] [CrossRef] [PubMed]
- Gupta, K.; Bhadelia, N. Management of urinary tract infections from multidrug-resistant organisms. Infect. Dis. Clin. N. Am. 2014, 28, 49–59. [Google Scholar] [CrossRef] [PubMed]
- Sukul, A.; Das, S.C.; Saha, S.K.; Rahman, S.A. Screening of analgesic, antimicrobial, cytotoxic and antioxidant activities of metal complexes of indomethacin. Dhaka Univ. J. Pharm. Sci. 2015, 13, 175–180. [Google Scholar] [CrossRef]
- Al-Bakri, A.; Othman, G.; Bustanji, Y. The assessment of the antibacterial and antifungal activities of aspirin, EDTA, and aspi-rin–EDTA combination and their effectiveness as antibiofilm agents. J. Appl. Microbiol. 2009, 107, 280–286. [Google Scholar] [CrossRef]
- El-Mowafy, S.A.; El Galil, K.H.A.; El-Messery, S.M.; Shaaban, M.I. Aspirin is an efficient inhibitor of quorum sensing, virulence and toxins in P. aeruginosa. Microb. Pathog. 2014, 74, 25–32. [Google Scholar] [CrossRef] [PubMed]
- Rubini, D.; Banu, S.F.; Subramani, P.; Hari, B.N.V.; Gowrishankar, S.; Pandian, S.K.; Wilson, A.; Nithyanand, P. Extracted chitosan disrupts quorum sensing mediated virulence factors in Urinary tract infection causing pathogens. Pathog. Dis. 2019, 77, ftz009. [Google Scholar] [CrossRef]
- Badawy, M.S.E.; Riad, O.K.M.; Taher, F.; Zaki, S.A. Chitosan and chitosan-zinc oxide nanocomposite inhibit expression of LasI and RhlI genes and quorum sensing dependent virulence factors of Pseudomonas aeruginosa. Int. J. Biol. Macromol. 2020, 149, 1109–1117. [Google Scholar] [CrossRef]
- Murray, T.; Ledizet, M.; Kazmierczak, B. Swarming motility, secretion of type 3 effectors and biofilm formation pheno-types exhibited within a large cohort of P. aeruginosa clinical isolates. J. Med. Microbiol. 2010, 59, 511–520. [Google Scholar] [CrossRef]
- Krishnan, T.; Yin, W.-F.; Chan, K.-G. Inhibition of quorum sensing -controlled virulence factor production in P. aeruginosa PAO1 by Ayurveda spice clove (Syzygiumaromaticum) Bud extracts. Sensors 2012, 12, 4016–4030. [Google Scholar] [CrossRef] [PubMed]
- Essar, D.; Eberly, L.; Hadero, A.; Crawford, I. Identification and characterization of genes for second anthranilate synthase in P. aeruginosa: Interchangeability of the two anthranilate synthases and evolutionary implications. J. Bacteriol. 1990, 172, 884–900. [Google Scholar] [CrossRef]
- Yahia, R.; Hanora, A.; Fahmy, N.; Aly, K. Quorum sensing signal production by sponge-associated bacteria isolated from the Red Sea, Egypt. Afr. J. Biotechnol. 2017, 16, 1688–1698. [Google Scholar] [CrossRef]
- CLSI Document M100-S28; Performance Standards for Antimicrobial Susceptibility Testing, 28th Informational Supplements. Clinical and Laboratory Standards Institute: Wayne, PA, USA, 2018.
- Das, M.C.; Sandhu, P.; Gupta, P.; Rudrapaul, P.; De, U.C.; Tribedi, P.; Akhter, Y.; Bhattacharjee, S. Attenuation of Pseudomonas aeruginosa biofilm formation by Vitexin: A combinatorial study with azithromycin and gentamicin. Sci. Rep. 2016, 6, 23347. [Google Scholar] [CrossRef] [PubMed]
- Hassan, R.; Shaaban, M.I.; Abdel Bar, F.M.; El-Mahdy, A.M.; Shokralla, S. Quorum sensing inhibiting activity of Streptomyces coelicoflavus isolated from soil. Front. Microbiol. 2016, 7, 659. [Google Scholar] [CrossRef]
- Gould, T.A.; Schweizer, H.P.; Churchill, M.E. Structure of the Pseudomonas aeruginosa acyl-homoserine lactone synthase LasI. Mol. Microbiol. 2004, 53, 1135–1146. [Google Scholar] [CrossRef]
- Colovos, C.; Yeates, T.O. Verification of protein structures: Patterns of nonbonded atomic interactions. Protein Sci. 1993, 2, 1511–1519. [Google Scholar] [CrossRef] [PubMed]
- Wainwright, M.; Maisch, T.; Nonell, S.; Plaetzer, K.; Almeida, A.; Tegos, G.P.; Hamblin, M.R. Photoantimicrobials—Are we afraid of the light? Lancet Infect. Dis. 2017, 17, e49–e55. [Google Scholar] [CrossRef] [PubMed]
- de Aledo, M.G.; González-Bardanca, M.; Blasco, L.; Pacios, O.; Bleriot, I.; Fernández-García, L.; Fernández-Quejo, M.; López, M.; Bou, G.; Tomás, M. CRISPR-Cas, a revolution in the treatment and study of ESKAPE infections: Pre-clinical studies. Antibiotics 2021, 10, 756. [Google Scholar] [CrossRef] [PubMed]
- Sharmin, S.; Rahaman, M.; Sarkar, C.; Atolani, O.; Islam, M.T.; Adeyemi, O.S. Nanoparticles as antimicrobial and antiviral agents: A literature-based perspective study. Heliyon 2021, 7, e06456. [Google Scholar] [CrossRef]
- Mousa, W.; Omar, N.; Riad, O.K.; Omran, M.E. Expression of bla-CTX-M and fimH genes in uropathogenic Escherichia coli isolated from Egyptian catheterized patients. Azhar Int. J. Pharm. Med. Sci. 2022, 2, 94–104. [Google Scholar] [CrossRef]
- Venkateswaran, P.; Vasudevan, S.; David, H.; Shaktivel, A.; Shanmugam, K.; Neelakantan, P.; Solomon, A.P. Revisiting ESKAPE Pathogens: Virulence, resistance, and combating strategies focusing on quorum sensing. Front. Cell. Infect. Microbiol. 2023, 13, 1159798. [Google Scholar] [CrossRef] [PubMed]
- Zaghloul, S.A.; Hashem, S.N.; El-Sayed, S.R.; Badawy, M.S.E.M.; Bukhari, S.I.; Selim, H.M.R.M.; Riad, O.K.M. Evaluation of the Cariogenic and Anti-Cariogenic Potential of Human Colostrum and Colostrum-Derived Probiotics: Impact on S. mutans Growth, Biofilm Formation, and L. rhamnosus Growth. Life 2023, 13, 1869. [Google Scholar] [CrossRef] [PubMed]
- Salem-Bekhit, M.M.; Riad, O.K.M.; Selim, H.M.R.M.; Tohamy, S.T.K.; Taha, E.I.; Al-Suwayeh, S.A.; Shazly, G.A. Box–Behnken Design for Assessing the Efficiency of Aflatoxin M1 Detoxification in Milk Using Lactobacillus rhamnosus and Saccharomyces cerevisiae. Life 2023, 13, 1667. [Google Scholar] [CrossRef]
- Abu-Elfotuh, K.; Selim, H.M.R.M.; Riad, O.K.M.; Hamdan, A.M.E.; Hassanin, S.O.; Sharif, A.F.; Moustafa, N.M.; Gowifel, A.M.; Mohamed, M.Y.A.; Atwa, A.M.; et al. The protective effects of sesamol and/or the probiotic, Lactobacillus rhamnosus, against aluminum chloride-induced neurotoxicity and hepatotoxicity in rats: Modulation of Wnt/β-catenin/GSK-3β, JAK-2/STAT-3, PPAR-γ, inflammatory, and apoptotic pathways. Front. Pharmacol. 2023, 14, 1208252. [Google Scholar] [CrossRef]
- Chanda, W.; Joseph, T.P.; Padhiar, A.A.; Guo, X.; Min, L.; Wang, W.; Lolokote, S.; Ning, A.; Cao, J.; Huang, M.; et al. Combined effect of linolenic acid and tobramycin on Pseudomonas aeruginosa biofilm formation and quorum sensing. Exp. Ther. Med. 2017, 14, 4328–4338. [Google Scholar] [CrossRef]
- Aboushleib, H.M.; Omar, H.M.; Abozahra, R.; Elsheredy, A.; Baraka, K. Correlation of quorum sensing and virulence factors in Pseudomonas aeruginosa isolates in Egypt. J. Infect. Dev. Ctries. 2015, 9, 1091–1099. [Google Scholar] [CrossRef] [PubMed]
- Liew, S.M.; Rajasekaram, G.; Puthucheary, S.A.; Chua, K.H. Antimicrobial susceptibility and virulence genes of clinical and environmental isolates of Pseudomonas aeruginosa. PeerJ 2019, 7, e6217. [Google Scholar] [CrossRef] [PubMed]
- Ali, A.; Ahmed, S. A review on chitosan and its nanocomposites in drug delivery. Int. J. Biol. Macromol. 2018, 109, 273–286. [Google Scholar] [CrossRef] [PubMed]
- Abd-El-Aziz, A.S.; Benaaisha, M.R.; Abdelghani, A.A.; Bissessur, R.; Abdel-Rahman, L.H.; Fayez, A.M.; El-Ezz, D.A. Aspirin-Based Organoiron Dendrimers as Promising Anti-Inflammatory, Anticancer, and Antimicrobial Drugs. Biomolecules 2021, 11, 1568. [Google Scholar] [CrossRef] [PubMed]
- Kanak, K.R.; Dass, R.S.; Pan, A. Anti-quorum sensing potential of selenium nanoparticles against LasI/R, RhlI/R, and PQS/MvfR in Pseudomonas aeruginosa: A molecular docking approach. Front. Mol. Biosci. 2023, 10, 1203672. [Google Scholar] [CrossRef] [PubMed]
- Maisetta, G.; Piras, A.M.; Motta, V.; Braccini, S.; Mazzantini, D.; Chiellini, F.; Zambito, Y.; Esin, S.; Batoni, G. Antivirulence Properties of a Low-Molecular-Weight Quaternized Chitosan Derivative against Pseudomonas aeruginosa. Microorganisms 2021, 9, 912. [Google Scholar] [CrossRef]
- Zhang, X.-P.; Wang, W.-H.; Tian, Y.; Gao, W.; Li, J. Aspirin increases susceptibility of Helicobacter pylori to metronidazole by augmenting endocellular concentrations of antimicrobials. World J. Gastroenterol. 2009, 15, 919–926. [Google Scholar] [CrossRef] [PubMed]
- Falcone, M.; Russo, A.; Shindo, Y.; Farcomeni, A.; Pieralli, F.; Cangemi, R.; Liu, J.; Xia, J.; Okumura, J.; Sano, M.; et al. A Hypothesis-Generating Study of the Combination of Aspirin plus Macrolides in Patients with Severe Community-Acquired Pneumonia. Antimicrob. Agents Chemother. 2019, 63, e01556-18. [Google Scholar] [CrossRef]
- Ahmed, E.F.; El-Baky, R.M.; Ahmed, A.B.; Waly, N.G.; Gad, G.F. Antibacterial activity of some non-steroidal anti-inflammatory drugs against bacteria causing urinary tract infection. Am. J. Infect. Dis. Microbiol. 2017, 5, 66–73. [Google Scholar] [CrossRef]
- Leão, C.; Borges, A.; Simões, M. NSAIDs as a Drug Repurposing Strategy for Biofilm Control. Antibiotics 2020, 9, 591. [Google Scholar] [CrossRef]

| Isolate No. | MIC of Aspirin | MIC of Chitosan | MIC of Aspirin in Combination | MIC of Chitosan in Combination | MIC of Ch.–Asp. | FIC Index | Interpretation |
|---|---|---|---|---|---|---|---|
| ps34 | 0.625 | 0.052 | 0.156 | 0.013 | 0.071 | 0.499 | Synergism |
| ps36 | 2.5 | 0.416 | 0.3125 | 0.052 | 0.071 | 0.25 | Synergism |
| ps37 | 1.25 | 0.416 | 0.156 | 0.104 | 0.017 | 0.37 | Synergism |
| ps45 | 1.25 | 1.666 | 0.3125 | 0.208 | 0.071 | 0.37 | Synergism |
| ps47 | 1.25 | 0.208 | 0.156 | 0.026 | 0.035 | 0.24 | Synergism |
| ps62 | 0.625 | 0.104 | 0.07 | 0.013 | 0.035 | 0.23 | Synergism |
| ps63 | 1.25 | 0.104 | 0.3125 | 0.026 | 0.143 | 0.5 | Synergism |
| ps88 | 1.25 | 0.104 | 0.156 | 0.013 | 0.143 | 0.24 | Synergism |
| ps99 | 1.25 | 0.104 | 0.156 | 0.013 | 0.143 | 0.24 | Synergism |
| ps100 | 1.25 | 0.208 | 0.3125 | 0.013 | 0.071 | 0.31 | Synergism |
| PAO1 | 0.156 | 0.052 | 0.07 | 0.0065 | 0.071 | 0.5 | Synergism |
|
Swimming Motility, 24 h. (mm) |
Swarming Motility, 24 h. (mm) |
Biofilm Formation (Å) | Pyocyanin (µg mL−1) | QS (Score) | ||||||||||||||||
|---|---|---|---|---|---|---|---|---|---|---|---|---|---|---|---|---|---|---|---|---|
| C | Ch | Asp. | Ch.–Asp. | C | Ch | Asp. | Ch.–Asp. | C | Ch | Asp. | Ch.–Asp. | C | Ch | Asp. | Ch.–Asp. | C | Ch | Asp. | Ch–Asp. | |
| PAO1 | 7 | 4 | 3 | 3 | 5 | 5 | 2 | 2 | 0.21 (+2) | 0.012 (0) | 0.018 (0) | 0.01 (0) | 19.88 | 7.68 | 11.41 | 6.196 | (0) | (0) | (0) | (0) |
| Clinical isolates | ||||||||||||||||||||
| ps34 | 6 | 6 | 4 | 3 | 4 | 4 | 3 | 2 | 0.22 (+2) | 0.011 (0) | 0.013 (0) | 0.009 (0) | 25.69 | 8.51 | 12.90 | 6.393 | (+2) | (+1) | (+1) | (0) |
| ps36 | 6 | 6 | 2 | 2 | 6 | 3 | 2 | 2 | 0.24 (+2) | 0.025 (0) | 0.025 (0) | 0.012 (0) | 8.826 | 5.83 | 7.68 | 5.852 | (+2) | (0) | (0) | (0) |
| ps37 | 7 | 7 | 3 | 3 | 5 | 3 | 2 | 2 | 0.26 (+2) | 0.01 (0) | 0.009 (0) | 0.008 (0) | 16.48 | 4.06 | 10.82 | 5.166 | (+2) | (0) | (+1) | (0) |
| ps45 | 5 | 3 | 3 | 3 | 7 | 3 | 2 | 2 | 0.2 (+2) | 0.012 (0) | 0.01 (0) | 0.013 (0) | 15.71 | 4.56 | 14.50 | 5.387 | (+2) | (+1) | (+1) | (+1) |
| ps47 | 5 | 5 | 3 | 3 | 6 | 3 | 3 | 3 | 0.23 (+2) | 0.014 (0) | 0.01 (0) | 0.009 (0) | 31.22 | 6.51 | 17.17 | 7.336 | (+2) | (+1) | (+1) | (+1) |
| ps62 | 6 | 6 | 3 | 3 | 7 | 4 | 2 | 2 | 0.24 (+2) | 0.016 (0) | 0.01 (0) | 0.01 (0) | 11.94 | 6.24 | 9.679 | 6.820 | (+2) | (0) | (0) | (0) |
| ps63 | 5 | 5 | 3 | 3 | 5 | 5 | 2 | 2 | 0.44 (+3) | 0.044 (0) | 0.011 (0) | 0.011 (0) | 28.61 | 7.57 | 13.21 | 4.228 | (+2) | (+1) | (+1) | (+1) |
| ps88 | 6 | 5 | 3 | 3 | 5 | 4 | 3 | 3 | 0.18 (+1) | 0.011 (0) | 0.009 (0) | 0.01 (0) | 23.74 | 3.82 | 11.11 | 7.323 | (+2) | (0) | (+1) | (+1) |
| ps99 | 6 | 4 | 4 | 3 | 6 | 5 | 5 | 2 | 0.18 (+1) | 0.097 (0) | 0.012 (0) | 0.011 (0) | 32.15 | 6.04 | 12.85 | 8.954 | (+2) | (0) | (+1) | (0) |
| ps100 | 7 | 4 | 3 | 3 | 5 | 4 | 2 | 2 | 0.21 (+2) | 0.01 (0) | 0.009 (0) | 0.01 (0) | 25.23 | 5.70 | 12.46 | 6.075 | (+2) | (0) | (+1) | (0) |
| Mean (n = 10) | 5.9 | 5.1 | 3.1 | 2.9 | 5.6 | 3.8 | 2.6 | 2.3 | 0.240 | 0.025 | 0.012 | 0.010 | 21.963 | 5.89 | 12.24 | 6.353 | 2 | 0.4 | 0.7 | 0.4 |
| ±SD | 0.7 | 1.2 | 0.6 | 0.3 | 1 | 0.8 | 1 | 0.5 | 0.075 | 0.027 | 0.005 | 0.001 | 8.192 | 1.47 | 2.623 | 1.337 | 0 | 5 | 0.5 | 0.5 |
| Cycle Threshold (CT) of LasI | Inhibition of LasI | Cycle Threshold (CT) of RhlI | Inhibition of RhlI | |||||||
|---|---|---|---|---|---|---|---|---|---|---|
| C | Ch. | Ch.–Asp. | Ch. | Ch.–Asp. | C | Ch. | Ch.–Asp. | Ch. | Ch.–Asp. | |
| PAO1 | 21.7 | 22.8 | 23.5 | 1.39 | 7.12 | 16.2 | 17.8 | 18.9 | 2.09 | 0.92 |
| Clinical isolates (n = 10) | ||||||||||
| ps34 | 18.7 | 23.0 | 21.0 | 84.5 | 1.0 | 13.7 | 23.0 | 21.0 | 2.70 × 103 | 2.28 × 102 |
| ps36 | 16.5 | 20.8 | 18.0 | 1.11 × 102 | 1.65 × 102 | 15.2 | 17.5 | 19.4 | 25.6 | 6.6 |
| ps37 | 13.0 | 19.3 | 18.9 | 5.26 × 102 | 1.40 × 102 | 16.4 | 22.6 | 39.0 | 4.71 × 102 | 1.83 × 107 |
| ps45 | 20.6 | 21.6 | 24.5 | 36.0 | 1.86 × 102 | 19.4 | 21.3 | 35.1 | 68.17 | 5.11 × 105 |
| ps47 | 24.8 | 26.8 | 26.8 | 7.76 | 5.87 | 20.8 | 23.5 | 24.1 | 12.99 | 4.51 × 102 |
| ps62 | 19.9 | 21.4 | 23.0 | 1.64 | 3.57 × 106 | 19.0 | 20.2 | 20.3 | 1.40 | 1.73 |
| ps63 | 16.2 | 18.1 | 37.0 | 16.73 | 4.34 × 103 | 16.2 | 18.1 | 33.6 | 16.73 | 3.41 × 105 |
| ps88 | 11.7 | 27.5 | 23.9 | 9.357 × 104 | 5.91 × 103 | 10.4 | 23.9 | 29.4 | 1.85 × 104 | 4.8 × 105 |
| ps99 | 20.4 | 32.0 | 32.2 | 2.70 × 103 | 3.95 × 109 | 14.1 | 16.3 | 16.7 | 3.802 | 9.53 |
| ps100 | 4.6 | 31.7 | 37.0 | 9.46 × 107 | 0.47 | 6.4 | 16.1 | 21.9 | 5.77 × 102 | 3.22 × 104 |
| Median | 17.6 | 22.3 | 24.23 | 98.08 | 1.76 × 102 | 15.8 | 20.7 | 23.05 | 46.91 | 1.63 × 104 |
Disclaimer/Publisher’s Note: The statements, opinions and data contained in all publications are solely those of the individual author(s) and contributor(s) and not of MDPI and/or the editor(s). MDPI and/or the editor(s) disclaim responsibility for any injury to people or property resulting from any ideas, methods, instructions or products referred to in the content. |
© 2024 by the authors. Licensee MDPI, Basel, Switzerland. This article is an open access article distributed under the terms and conditions of the Creative Commons Attribution (CC BY) license (https://creativecommons.org/licenses/by/4.0/).
Share and Cite
Badawy, M.S.E.M.; Riad, O.K.M.; Harras, M.F.; Binsuwaidan, R.; Saleh, A.; Zaki, S.A. Chitosan–Aspirin Combination Inhibits Quorum-Sensing Synthases (lasI and rhlI) in Pseudomonas aeruginosa. Life 2024, 14, 481. https://doi.org/10.3390/life14040481
Badawy MSEM, Riad OKM, Harras MF, Binsuwaidan R, Saleh A, Zaki SA. Chitosan–Aspirin Combination Inhibits Quorum-Sensing Synthases (lasI and rhlI) in Pseudomonas aeruginosa. Life. 2024; 14(4):481. https://doi.org/10.3390/life14040481
Chicago/Turabian StyleBadawy, Mona Shaban E. M., Omnia Karem M. Riad, Marwa F. Harras, Reem Binsuwaidan, Asmaa Saleh, and Samar A. Zaki. 2024. "Chitosan–Aspirin Combination Inhibits Quorum-Sensing Synthases (lasI and rhlI) in Pseudomonas aeruginosa" Life 14, no. 4: 481. https://doi.org/10.3390/life14040481
APA StyleBadawy, M. S. E. M., Riad, O. K. M., Harras, M. F., Binsuwaidan, R., Saleh, A., & Zaki, S. A. (2024). Chitosan–Aspirin Combination Inhibits Quorum-Sensing Synthases (lasI and rhlI) in Pseudomonas aeruginosa. Life, 14(4), 481. https://doi.org/10.3390/life14040481

